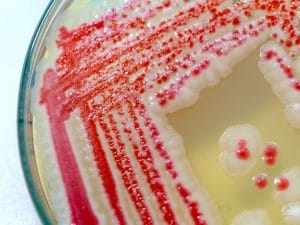

I due neonati morti all’ospedale di Bolzano hanno contratto un’infezione nosocomiale da Serratia, un batterio spesso coinvolto in epidemie in strutture neonatali. Entrambi i piccoli, nati prematuri, hanno sviluppato una sepsi risultata fatale.
Continua a leggere
